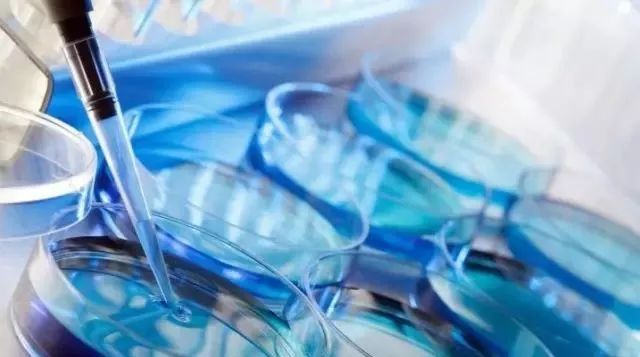
试管婴儿

电话:19919999145
微信:17027022222
邮箱:kf@daiyun.cn
地址:国内、马来西亚、吉尔吉斯斯坦
发布时间:2021-11-18 点此:624次
从1978年“世纪之婴”路易斯.布朗诞生至今,全世界通过辅助生殖技术诞生的婴儿已有600万名左右。发展至今,人类辅助生殖领域涵盖了人工授精,体外受精-胚胎移植(试管婴儿)及衍生技术和捐卵捐精,冷冻卵子胚胎,代孕,彩虹宝贝等的各种医疗形式。
采用代孕生子的明星如今已有一串长长的名单,其中最大牌的恐怕就是射门员C罗和妮可基德曼了。C罗对这种独特的“射术”还情有独钟,继迷你罗后,如今又通过代孕得到一对龙凤胎。

而之前徐静蕾坦承赴美冻卵一度成为热门话题,女性冻卵恰恰也是辅助生殖技术飞速发展过程中与时代趋势相结合的产物。
试管婴儿如今已发展至第三代技术胚胎植入前遗传学检测(PGS/PGD)。PGS通过对染色体数目和结构对比分析来检测胚胎是否有遗传物质异常。PGD则对胚胎遗传物质分析,筛选健康胚胎移植。美国是目前拥有最丰富的辅助生殖技术临床经验,最完善的政府监管及世界上最高的试管婴儿成功率的国家。

美国目前走在第三代试管技术的最前列,经过二十多年的临床应用积累了极为成熟的经验。第三代技术不仅有效防止遗传疾病传递,也使性别鉴别在胚胎植入前成为可能。因此双胞胎,龙凤胎在试管婴儿中的比例大大提高。

美国加州更是集中了全美最多的辅助生殖诊所,拥有数量众多的世界顶级胚胎实验室和一流专家。并且无论从相关行业配套(专业辅助生殖领域律师,心理评估师,代母招募公司…)的完善,实施的周期数量还是从法律的完备和对代孕的友好态度来说,加州都是当之无愧试管婴儿孕育和同性人群求子的世界圣地,没有之一!

这里吸引着全球无数有需求人士前来圆梦。
以上就是爱之晶IVF给大家介绍的相关内容,如果您还想了解更多的事项可以拨打我们的热线电话,可以点击我们的官网在线实时咨询我们,或者关注我们的官方微信公众号,我们会有专业的工作人员为您解答。